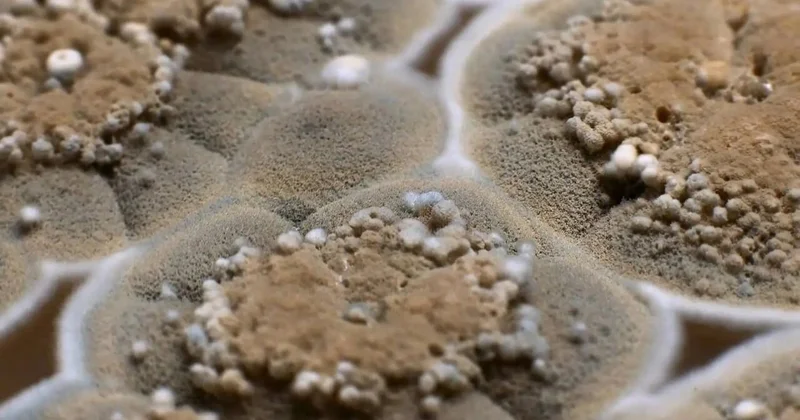
Evdə nəmlik və kifə qarşı 7 effektli bitki Ekspert məsləhəti ilə

Növbəti mövsümdə çempion olmağa borcluyuq Mikel Arteta
Icma.az, Fanat portalından verilən məlumatlara əsaslanaraq xəbər verir.
London "Arsenal"ının baş məşqçisi Mikel Arteta növbəti mövsüm üçün qarşıya qoyduqları hədəfi açıqlayıb.
Fanat.Az xəbər verir ki, ispaniyalı mütəxəssisin sözlərini tanınmış insayder Fabritsio Romano şəxsi "X" hesabı üzərindən belə çatdırıb:
"Arsenal"ın "Real"dan Rodriqonu transfer edəcəyini deyirlər? Ad çəkməyəcəm, amma klubu elə duruma gətirmişik ki, növbəti mövsümdə çempionluq əldə etməyə məhkumuq. "Arsenal"ın İngiltərədə olduğu kimi, Avropada da elit komanda sayılmasına şübhə yoxdur".
Xatırladaq ki, 71 xala malik "Arsenal" hazırda İngiltərə Premyer Liqasının turnir cədvəlində 2-ci pillədə mövqe tutub.
Nihat
Bu mövzuda digər xəbərlər:Şanslar hələ bərabərdir Mikel Arteta
30 Aprel 2025 09:50
Mikel Arteta 1:0ı şərh etdi
28 Dekabr 2024 11:54
Mikel Arteta adını Arsenalın tarixinə yazdırıb
05 Dekabr 2024 11:48
Bu, xüsusi axşam idi Mikel Arteta
05 Dekabr 2024 17:48
Real ı məğlub etməyə hazırıq Mikel Arteta
08 Aprel 2025 14:24
Baxış sayı:119
Bu xəbər 22 May 2025 17:48 mənbədən arxivləşdirilmişdir



Daxil ol
Online Xəbərlər
Xəbərlər
Hava
Maqnit qasırğaları
Namaz təqvimi
Kalori kalkulyatoru
Qiymətli metallar
Valyuta konvertoru
Kredit Kalkulyatoru
Kriptovalyuta
Bürclər
Sual - Cavab
İnternet sürətini yoxla
Azərbaycan Radiosu
Azərbaycan televiziyası
Haqqımızda
TDSMedia © 2025 Bütün hüquqlar qorunur







Günün ən çox oxunanları